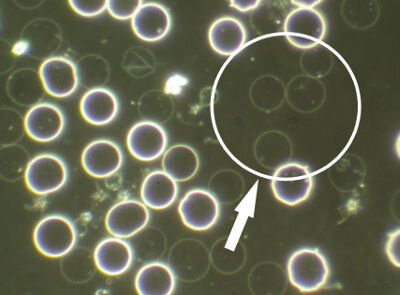

Good Fat, Bad Fat, Healthy Fat, Low Fat! Insights From LBA
My grandmother used to save the dripping from the Sunday roast and ceremoniously offer it up to us when we visited. We would dunk a chunk of bread in the solid white fat; it would crack like ice on a pond to reveal the jelly like rich gravy underneath and the bread soaked it up. Delicious!
Most people will shudder at the thought of eating the dripping now because for decades we’ve been led to believe that saturated fat is bad for our health, especially animal fat. We’ve been taught that eating fat will make us fat and could cause heart disease.
But fat is a vital nutrient that our body requires in order to be healthy.
As a nutritionist, I often need to inform my clients of the science around dietary fats and the role they play in health and disease to be able to persuade them that:
“Yes, you can eat fat – even saturated fat - and be healthy”.
But often clients are not so easily convinced, until they see their blood during an analysis session!
Considering how important to health our red blood cells are, it is vital that they are able to withstand the pressures they are under during circulation in order for them to deliver the essential-to-life oxygen to all our cells, tissues and organs.
If clients are consuming high levels of refined and processed fats, eating a diet of predominantly polyunsaturated fats and have little to no animal fats in their diet - it will show up in the blood in various ways:
If the membranes are not formed properly – the red blood cells will lose their integrity in circulation.
Hemolysed Red Blood Cell
The rbc membranes will also oxidise easily creating red blood cells that are unable to carry out their functions.
Echinocytes
If the rbc membrane is deformed due to lack of appropriate fats they break under circulatory pressure. (picture of acanthocytes)
Acanthocytes
Is fat essential to health?
Yes! Healthy fats are essential for healthy cell membranes, especially red blood cells, and unhealthy fats can create unhealthy cell membranes which, if not corrected, can be responsible for many health issues:
Dietary fats are a source of energy – double the energy content of protein or carbohydrate.
They function as structural building blocks of the body –providing every cell with a membrane which contains a combination of different fats that together create stability and flexibility for the cells.
Fats carry fat-soluble vitamins, A, D, E and K, and support their absorption in the intestine. Consuming sufficient amounts of fatty foods that contain these vitamins is essential for adequate intake of these vital micronutrients.
Fats are indispensable for a number of important biological functions including growth and development.
The brain is very rich in fat (60%) and has a unique fatty acid composition; docosahexaenoic acid (DHA) is the major brain fatty acid. The lipids of the retina also contain very high concentrations of DHA.
Essential fatty acids, which are derived from dietary polyunsaturated fats via a very complex and sensitive biological conversion – are necessary for brain and eye health, hormonal balance, inflammatory response regulation, blood clotting and wound healing.
Considering this long, but by no means exhaustive list of the benefits of fat, when did fat become associated with bad health and why?
“Fat makes you Fat”
Just before the turn of the 19th century food started to be measured in calories. Of the three macromolecules of nutrition – fat, carbohydrate and protein – fat contains the most calories. By the 1920s the desired shape and size of women’s bodies changed from plump and voluptuous, which indicated wealth and health - to stick thin and flat chested being the in vogue female image.
The word calorie became associated with dieting and soon women were counting calories and seeking to eat less and less of them in an effort to maintain the fashion industry’s promoted skinny ideal.
And so began the dieting culture.
This led to eating habits that aimed to reduce calories, but paid little attention to the nutrient values of the foods. Diets evolved to contain less fat, more carbohydrates and foods rich in sugar.
But – we’ve reduced our fat calorie intake and yet today one in 3 of us is obese?
“Fats are bad for your heart”
In the 1920s clogged arteries were a rarity and only a small branch of medicine was concerned with coronary heart disease. A few heart specialists would meet occasionally to discuss their few cases and formed the American Heart Association in 1924.
A researcher called Ancel Keys presented the Lipid Hypothesis in the late 1950s. It stated that there was a direct relationship between the amount of saturated fat and cholesterol in the diet – specifically the traditional animal fats - and the incidence of coronary heart disease.
Around the same time the cotton industry discovered a processing technique that turned a waste product, cotton seed oil, into a fat that can be used as a replacement for butter, lard and in commercial baking and sold as a food ingredient known as ‘Crisco’. This product soon became a household staple around the world.
However, there were no safety tests done to make sure this was a product fit for human consumption. Despite this, the lipid hypothesis took hold and research bodies, such as the American Heart Association enjoyed huge financial support from the burgeoning refined food oil industry.
The fats that made up our diet changed quite drastically due to the advice given by medical institutions to cut down on the traditional butter and lard and consume refined vegetable oil instead, in an effort to reduce the rising heart disease epidemic.
But – we’ve cut out our saturated animal fat and yet today heart disease is the number one killer in the world?
Between 1920 and the year 2000 -
The proportion of traditional animal fats in diet declined from 83% to 62%
Consumption of sugar and processed foods increased by 60%
Yet dietary vegetable oils intake increased by 400%!
Within just 80 years heart disease went from a few rare cases to one in three deaths globally!
Our diets have changed, we are consuming fewer calories as fat, and we are consuming massively increased levels of processed vegetable fats and refined carbohydrates.
Could plant-based fats be bad for our health?
Humans have always consumed polyunsaturated fats as part of the diet in the form of legumes, grains, nuts, green vegetables, fish, olive oil and animal fats – but not as processed and refined vegetable oils. Modern diets typically contain around 30% of its calories as polyunsaturated fat from soy, corn, safflower and canola oils.
Yet the evidence from scientific research supporting the lipid hypothesis is not conclusive. In fact it indicates that we should not be consuming more than 4%.
These volatile polyunsaturated oils are damaged by the heat and pressure they are put under in order to extract the oil from the raw product. It changes the molecular structure of the delicate oils.
In order to make the finished product palatable it is treated with deodorants, bleach and chemical preservatives, flavourings and colours.
All of this refining and processing may lead to a convenient palatable product that can be used in cooking and food product manufacturing but it has caused so much damage to our health that today, the levels of these dangerous fats – known as trans-fat - allowed in food has been reduced enormously, in some countries even banned.
We now know just how unhealthy trans-fats are, causing:
Oxidation and free radical damage to all cells
Cell membrane oxidation and abnormalities
Damage DNA/RNA causing mutations in cell reproduction
Premature aging of the skin
Damage to tissues and organs
Damage to blood vessels which can lead to a build-up of plaque
Trans fats can also:
Block the use of essential fatty acids –affecting the central nervous and endocrine systems
Increase blood cholesterol levels
Raise inflammatory responses and trigger autoimmune diseases
Consumption of these oils in this quantity has been shown to contribute to disease conditions such as cancer, heart disease, immune system dysfunction, damage to liver, reproductive organs and lungs, digestive disorders, learning and growth impairment and weight gain.
Free radical damage that can be triggered by consuming damaged fats is associated with premature aging, autoimmune diseases, inflammatory responses that are linked to heart disease, stroke, diabetes, contributes to insulin resistance.
How to improve your diet and use Live & Dry Blood Analysis to monitor progress
You can use Live & Dry Blood Analysis to check the levels of oxidative stress and lipid peroxidation of your red blood cell membranes.
We all have damaged fats in our organs, tissues and cells. If you change the fats you consume, in time, your body will replace the damaged fats with the healthy ones.
Top tips for ensuring you eat plenty of healthy fats
The best thing you can do for your health is to eliminate processed, refined oils and fat - no margarine, odourless golden vegetable oil liquid, foods cooked in those oils (crisps), or food products produced using those oils (pastry, cakes, biscuits etc).
Include healthy fats in all your meals - make sure you eat a range of different fats throughout your week to get the benefits:
You need unrefined, cold pressed nut and seed oils such as EVOO, flaxseed/linseed oil – these will be full of antioxidants and unspoiled by processing, contained in dark glass bottles and kept cool, sealed and away from light.
Plant based healthy fats - coconut oil, avocados, raw and soaked nuts and seeds, green leafy vegetables, fermented nut cheese, nut and seed milks and yoghurts, chia seeds and even cacao nibs!
Other healthy fats – if you consume animal products it is essential that you choose the highest welfare producers and check the provenance of the product.
Grass fed, unpasteurised, organic butter, milk and cheese contain very important healthy fats. Unprocessed, grass fed, naturally raised organic meat, cooked slowly to break down the fast and enrich the meal with minerals from the bones. Organ meats are very high in healthy fats too.
Make the necessary dietary changes and after 120 days, when all of your blood cells have been replaced with new ones, you can check the blood again under the microscope and see the difference.
If you would like to know more about Live and Dry Blood Analysis Training so that you can use it to assess your clients’ health then please follow this link.
You are also invited to join our Facebook Group ‘Learning Live Blood Analysis’ - a private group of students, qualified analysts and anyone interested in learning.
If you have any questions about this topic or LDBA in general please email Shirah directly at info@naturecureacademy.com or add a comment below!